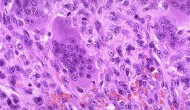

缺乏明顯療效是新藥開發(fā)失敗的最重要原因。雖然動物和人,疾病模型和疾病本身有著巨大區(qū)別,但實驗動物模型依然是預測后期臨床療效,降低臨床開發(fā)風險的最重要步驟之一。
Continue reading …
今天哈佛教授Jerry Avorn在NEJM上發(fā)表文章質疑去年塔夫茨估計的26億美元新藥研發(fā)成本。這位教授高度懷疑26億美元的可靠性,并指出塔夫茨的分析不夠透明,無法核實。
Continue reading …Immunomedics的SN-38抗體藥物偶聯(lián)物(ADC)Sacituzumab Govitecan獲得FDA快速通道認定
2015年5月21日 Immunomedics的SN-38抗體藥物偶聯(lián)物(ADC)Sacituzumab Govitecan獲得FDA快速通道認定已關閉評論
Immunomedics制藥公司的SN-38抗體藥物偶聯(lián)物(ADC)sacituzumab govitecan最近又獲得FDA的一項快速通道(fast track)認定,用于治療至少經(jīng)過2次化療、靶向療法(包括ALK或EGFR抑制劑)或免疫療法(包括PD-1抑制劑)等治療但依然進展的轉移性非小細胞肺癌。
Continue reading …
前一陣網(wǎng)上有一個段子, 大概意思是某廠的香皂包裝生產(chǎn)線常常會有盒子里沒裝入香皂。他們請了一個學自動化的博士后設計一個方案來分揀空的香皂盒。博士后拉起了一個十幾人的科研攻關小組,綜合采用了機械、微電子、自動化、X射線探測等技術,成功解決了問題。
Continue reading …
歐洲藥物化學聯(lián)盟(European Federation of Medicinal Chemistry)正在舉行一次有趣的競賽,內(nèi)容是如何用一分鐘之內(nèi)的短片解釋為什么藥物化學很重要、藥物化學是干什么的。
Continue reading …
手術、化療、放療、靶向療法、和免疫療法是當今癌癥治療的五大支柱。本人對生物只有皮毛的了解,今天就作為一個門外漢講講我對這些腫瘤治療手段的看法。一般人心目中的腫瘤是生長失控的細胞,好像除了超生也沒有太多其它不良行為。
Continue reading …
如果說癌癥免疫療法是最近幾年抗腫瘤研究最大突破的話,抗體藥物偶聯(lián)物(Antibody Drug Conjugate,ADC)可能是當下新藥研發(fā)技術上的最大熱點。
Continue reading …
帕金森癥是一種慢性、漸進性、神經(jīng)退行性疾病。多發(fā)于老年患者,導致運動障礙、自主神經(jīng)功能紊亂、情緒和認知障礙的疾病。帕金森癥的后遺癥包括:生活質量下降、勞動能力喪失、醫(yī)療保健支出增加等。
Continue reading …
人體免疫系統(tǒng)能識別并摧毀外來物。除了細菌、病毒,遞送藥物的納米粒子、植入的起搏器和人工關節(jié)等也是外來物,同樣會引發(fā)免疫反應,導致藥物失效、排斥或發(fā)炎。據(jù)物理學家組織網(wǎng)2月21日報道,美國賓夕法尼亞大學科學家開發(fā)出一種新方法,給這些治療設備貼上蛋白質“通行證”,讓它們能順利通過人體的防御系統(tǒng)。
Continue reading …
美國加州大學洛杉磯分校(UCLA)今天宣布,該校以Yi Tang教授為首的研究人員發(fā)明了一種可降解的納米級的膠囊,可以靶向性地把包括蛋白質或核酸等大分子輸送至癌細胞,有效地抑制癌細胞的生長,而且不損傷健康組織。
Continue reading …潛在應用:COPD (慢性阻塞性肺病) 基本原理: 二肽基肽酶(Dipeptidyl peptidase 1 […]
Continue reading …應用:腫瘤 基本原理: 小GTP酶是細胞活性的關鍵調節(jié)分子,并是人類疾病特別是腫瘤中應用小分子抑制劑的新型治療 […]
Continue reading …

微信號:美中藥源
微信號:美中藥源